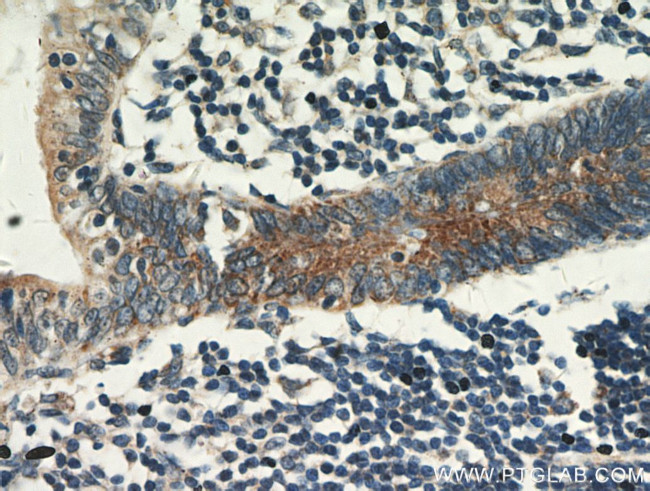
CCDC93 Antibody in Immunohistochemistry (Paraffin) (IHC (P))

Search
Proteintech
CCDC93 Polyclonal Antibody
{{$productOrderCtrl.translations['antibody.pdp.commerceCard.promotion.promotions']}}
{{$productOrderCtrl.translations['antibody.pdp.commerceCard.promotion.viewpromo']}}
{{$productOrderCtrl.translations['antibody.pdp.commerceCard.promotion.promocode']}}: {{promo.promoCode}} {{promo.promoTitle}} {{promo.promoDescription}}. {{$productOrderCtrl.translations['antibody.pdp.commerceCard.promotion.learnmore']}}
产品信息
20861-1-AP
种属反应
已发表种属
宿主/亚型
分类
类型
抗原
偶联物
形式
浓度
规格
纯化类型
保存液
内含物
保存条件
运输条件
产品详细信息
Immunogen sequence: CSAEIKQIV SEYAEKQSEL SAEESPEKLG TSQLHRRKVI SLNKQIAQKT KHLEELRASH TSLQARYNEA KKTLTELKTY SEKLDKEQAA LEKIESKADP SILQNLRALV AMNENLKSQE QEFKAHCREE MTRLQQEIEN LKAERAPRGD EKTLSSGEPP GTLTSAMTHD EDLDRRYNME KEKLYKIRLL QARRNREIAI LHRKIDEVPS RAELIQYQKR FIELYRQISA VHKETKQFFT LYNTLDDKKV YLEKEISLLN SIHENFSQAM ASPAARDQFL RQMEQIVEGI KQSRMKMEKK KQENKMRRDQ LNDQYLELLE KQRLYFKTVK EFKEEGRKNE MLLSKVKAKA S (282-631 aa encoded by BC028609)
靶标信息
CCDC93 is involved in copper-dependent ATP7A trafficking between the trans-Golgi network and vesicles in the cell periphery; the function is proposed to depend on its association within the CCC complex and cooperation with the WASH complex on early endosomes and is dependent on its interaction with WASHC2C.
仅用于科研。不用于诊断过程。未经明确授权不得转售。
生物信息学
蛋白别名: coiled-coil domain containing 93; Coiled-coil domain-containing protein 93; unnamed protein product
基因别名: 4633402D15Rik; 9230102M16Rik; CCDC93
UniProt ID: (Human) Q567U6, (Mouse) Q7TQK5, (Rat) Q5BJT7
Entrez Gene ID: (Human) 54520, (Mouse) 70829, (Rat) 304743